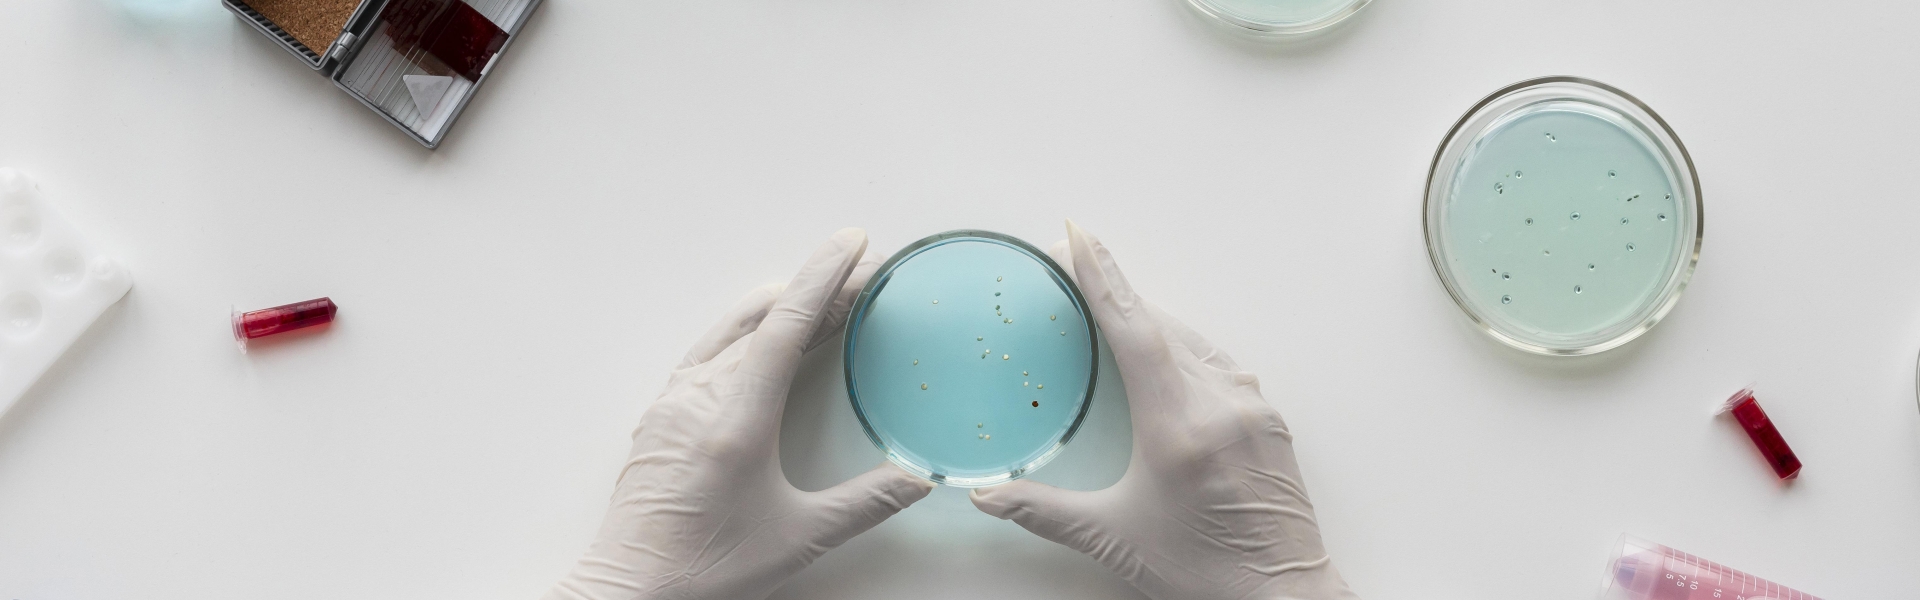
T1913/21

T1913/21: technical use or process? Clarifying the limits of G2/88
In T1913/21, the decision of the Opposition Division (OD) to maintain the patent as amended in the form of the main request was appealed by both opponents.
The claim held allowable by the OD can be summarised as the ‘use of pyruvates, having effect of reducing the formation of trisulfide bonds, on the production of proteins’. The proprietor (P) argued that for the prior art to be novelty destroying it had to disclose one of the cited pyruvates used for obtaining the same technical effect. In the P’s view, the amended claims did not lack novelty as the prior art failed to disclose said effect. The P was of the view that said new technical effect led to a new use, namely the use of such compounds to prevent trisulfide bond formation by inhibiting cysteine degradation. The Opponents (O) argued that the effect of reducing the formation of trisulfide bonds was a technical effect underlying the known purpose of protein production. As such the subject-matter could not be novel.
The Board arrived to the conclusion that the jurisprudence of G2/88 and G6/88 apply to use claims. Despite the claim comprising the term ‘use’ the claimed subject matter comprises carrying out process steps which result in the production of a product and is thus a process claim. The proteins resulting from the claimed process would be covered by Art.64(2) EPC as ‘products directly obtained’ by the claimed process. As such, claiming the use of a known product while merely reciting an apparently novel effect—such as the reduction of trisulfide bonds—does not constitute a technical feature limiting the claimed “use”. The board thus revoked the patent for a lack of novelty and the request for referred to the Enlarged Board of Appeal [EboA] was rejected.
Background
In the decision under appeal, the interlocutory decision of the OD to maintain the European Patent 2707383 as amended was appealed by two parties.
Independent claim 1 as held allowable reads:
Use of an inhibitor of cysteine degradation for reducing the formation of trisulfide bonds in proteins, wherein the inhibitor of cysteine degradation is selected from pyruvate, methyl pyruvate, ethyl pyruvate, glyceraldehyde, and glyoxylic acid; and wherein the use comprises: culturing cells expressing said proteins in the presence of an effective amount of the inhibitor of cysteine degradation, whereby trisulfide linkage formation in said proteins is reduced relative to cells cultured in medium without the inhibitor of cysteine degradation.
The OD considered that the claim was not merely directed to the use of pyruvate for producing proteins with reduced trisulfide bonds, but rather to the use of pyruvate to reduce trisulfide bond formation—a new property attributed to pyruvate in cell culture. The OD stated that a novelty anticipating document must disclose the use of the same substance in the same method for obtaining the same effect and that the disclosure of the underlying mechanism is irrelevant. In the absence of said prior art, the claim was maintained in amended form.
The crucial issue in the appeal was how the use claim should be interpreted: i) as the use of pyruvate in protein production, regardless of whether it relates to the reduction of trisulfide bonds, or ii) as a use specifically limited by the technical effect of reducing trisulfide bond formation.
The P argued that the claim is a non-medical use claim for achieving the effect of ‘reducing the formation of trisulfide bonds’ which is not mentioned in the prior art. Furthermore, the claimed use relates to a new way of exploiting the newly recognized property since it enables large scale processing of proteins whilst avoiding separate purification steps resulting from trisulfide bond formation. The prior art only disclosed pyruvates without providing any indication that the claimed compounds could be used to prevent trisulfide bond formation.
In the O’s view the claim should be construed as a process claim for the production of proteins. As such, the claim should be understood as relating to (any) use of pyruvate in protein production, regardless of whether or not such a use related to the reduced formation of trisulfide bonds. As per T1855/06 the use of a compound for the production of a product has to be interpreted as a process for production of the product with the compound. It can be regarded as novel only if the process of production as such is novel; on this basis, the present claim lacks novelty over the prior art.
Other Case Law
The Board relied on the jurisprudence of G2/88 and G6/88. These decisions state that a claim to the use of a known compound for a particular purpose, which is based on a technical effect which is described in the patent, should be interpreted as including that technical effect as a functional feature. Such claims are not open to objection under A.54(1) EPC provided that the technical feature has not previously been made available to the public. Such decisions apply to second non-medical use claims that do not result in a product.
Decision of the Board
The Board disagreed with the OD’s analysis.
The Board was of the view that decisions G2/88 and G6/88 could be applied herein. However, the teaching of G2/88 applies with caution and a distinction should be made between ‘use’ of a process to produce a product or use to achieve a new technical effect.
The Board viewed the claim as a process claim, as the claimed-subject matter encompasses process steps which result in the production of a product (r.20). Despite the claim being drafted as the ‘use’ of a chemical compound, the technical effect of reduced formation of trisulfide bonds could not occur except as part of a process for producing proteins. The Board stated that a
The Board considered the claim notionally equivalent to a claim to a ‘process including the step of using the compound’. According to Art.64(2) EPC, when the subject-matter of the European patent is a process, the protection conferred by the patent shall extend to the products directly obtained by such process. As the prior art disclosed a process wherein cells were cultured in the presence of pyruvate for the production of recombinant proteins, the claim lacked novelty. The technical effect of ‘reducing the formation of trisulfide bonds’ which was not disclosed in the prior art could not be used to attain patent protection for an already known product.
The P’s request for a referral to the EBoA, arguing that the Board’s approach deviated from G2/88 was rejected. The Board set the decision under appeal aside and the patent was maintained as granted.
Summary written by the NLO EPO Case Law Team
